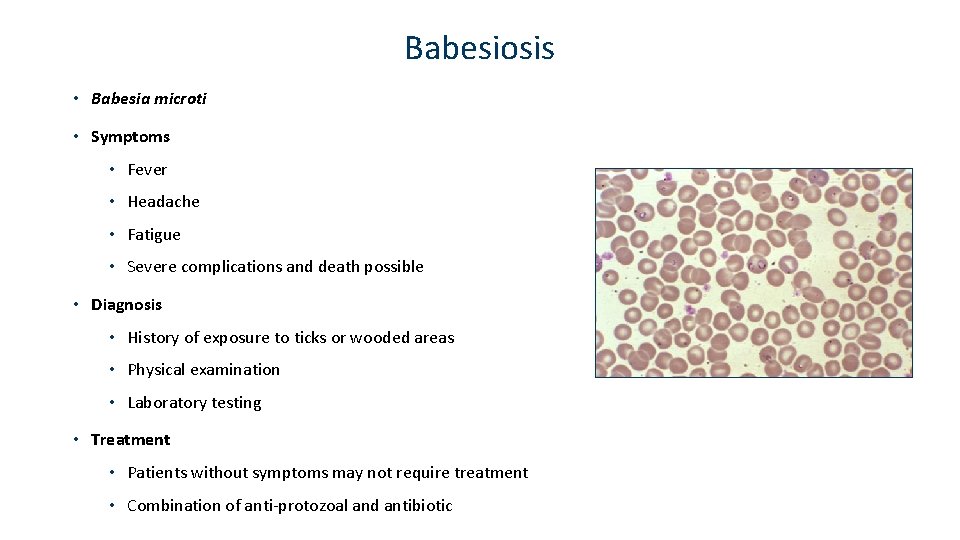
Babesiosis • Babesia microti • Symptoms • Fever • Headache • Fatigue • Severe

Ticks Tickborne Diseases of Minnesota Vectorborne Diseases Unit

Ticks & Tickborne Diseases of Minnesota Vectorborne Diseases Unit Last Updated July 8, 2019

What is a tickborne disease and why should you care about it? • People can get a tickborne disease when they are bitten by a tick that is infected with a disease agent • The number of people getting tickborne diseases is increasing throughout the United States, including Minnesota • Personal protection methods can help keep you safe from tick bites and tickborne diseases while enjoying healthy outdoor activities

Goals of Presentation • Be able to recognize ticks of public health concern in MN • Be aware of tickborne diseases • Recognize basic signs and symptoms • Seek early diagnosis and treatment • Know when and where tickborne disease risk is highest • Practice prevention methods • Know who to contact for more information

3 Main Ticks of Public Health Concern in Minnesota Blacklegged (Deer) Tick Lyme disease Anaplasmosis Babesiosis Ehrlichiosis Powassan virus disease Borrelia miyamotoi disease American Dog (Wood) Tick Rocky Mountain Spotted Fever Tularemia Lone Star Tick Ehrlichiosis Tularemia Heartland virus disease Bourbon virus disease Southern Tick-Associated Rash Illness (STARI)

Tick Life Stages

Blacklegged Tick Life Cycle

Blacklegged Tick Life Stages Nymph Larva Adult

Engorged Adult Female Blacklegged Tick

Questing What blacklegged ticks do: • Search for a host from the tips of low-growing vegetation • Sense body chemicals and other cues from potential hosts • Climb onto a person or animal near ground level as they walk by What blacklegged ticks don’t do: • Jump • Fly • Fall from treetops • See

Blacklegged Tick Habitat

Tickborne Disease Risk in Minnesota Photo courtesy of MN Department of Natural Resources (accessed 2/16/2018) http: //www. dnr. state. mn. us/biomes/index. html

Distribution of Blacklegged Tick Populations by County in Minnesota


Reported Tickborne Disease Cases in Minnesota, 1996 -2018 1600 Number of Cases 1400 1200 1000 800 600 400 200 0 1996 1997 1998 1999 2000 2001 2002 2003 2004 2005 2006 2007 2008 2009 2010 2011 2012 2013 2014 2015 2016 2017 2018 Year of Diagnosis Lyme disease Anaplasmosis Babesiosis

What are the symptoms of a tickborne disease? • Many tickborne diseases have similar symptoms • Initial symptoms usually show up within 2 -4 weeks of being bitten by an infected tick • Watch for symptoms like: • Rash • Fever • Headache • Fatigue • Muscle or joint aches

How are tickborne diseases diagnosed? • If you think that you may have a tickborne disease, contact your health care provider as soon as possible • Your health care provider can determine if you have a tickborne disease based on your: • History of being around wooded or brushy areas (where ticks may live) • Physical examination • Laboratory tests

Are tickborne diseases treatable? • Most tickborne diseases are treatable • For most people, the prognosis is good and symptoms go away after treatment • Talk with your health care provider about managing symptoms that have not resolved after treatment

Lyme Disease • Borrelia burgdorferi • Symptoms • Characteristic Rash (erythema migrans) • Fever • Muscle or joint pain • Fatigue • Diagnosis • History of exposure to ticks or wooded areas • Physical examination • Laboratory testing • Treatment • Antibiotics

Anaplasmosis • Anaplasma phagocytophilum • Symptoms • Fever • Severe headache • Muscle or joint pain • Severe complications and death possible • Diagnosis • History of exposure to ticks or wooded areas • Physical examination • Laboratory testing • Treatment • Antibiotics
Babesiosis • Babesia microti • Symptoms • Fever • Headache • Fatigue • Severe complications and death possible • Diagnosis • History of exposure to ticks or wooded areas • Physical examination • Laboratory testing • Treatment • Patients without symptoms may not require treatment • Combination of anti-protozoal and antibiotic

Rare/Emerging Tickborne Disease Agents in Minnesota Powassan virus Ehrlichia muris eauclairensis Borrelia mayonii Borrelia miyamotoi Rickettsia rickettsii* Francisella tularensis* *transmitted by the American dog (wood) tick, not the blacklegged tick

Protect Yourself from Tickborne Diseases 1) Know when and where you’re at risk • Primarily Mid-May through mid-July • Wooded and brushy areas – Blacklegged tick • Grassy or wooded areas – American dog tick 2) Wear EPA-registered tick repellent • DEET 20 -30% on skin or clothing • Permethrin 0. 5% on clothing 3) Check yourself for ticks • Undress and shower after being outdoors • Check at least once a day • Remove ticks ASAP!

How to Remove a Tick

Other Tick Prevention Methods Tumble dry clothing on high for ≥ 6 (dry) - 60 (wet) minutes Keep lawn and trails mowed short Remove leaf litter and brush Create a barrier between your yard and woods Talk with your vet about tick preventatives for your pets Image courtesy of Kirby Stafford, Connecticut Agricultural Experiment Station, New Haven

Be Aware of Tickborne Disease Symptoms Contact your doctor if you notice: Rash Fever Headache Fatigue Muscle or joint aches

Thank You! Questions? Minnesota Department of Health Vectorborne Diseases Unit 625 North Robert Street PO Box 64975 Saint Paul, MN 55164 -0975 651 -201 -5414 http: //www. health. state. mn. us/ticks
- Slides: 26